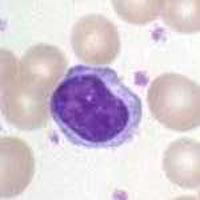

Nuova tecnica per esaminare i globuli bianchi
Alcuni ricercatori nel Regno Unito e in Belgio hanno sviluppato una nuova tecnica di colorazione potenzialmente utile per chiarire lo sviluppo di molti tipi di cancro comunemente diffusi e dell'infezione da HIV, nonché per approfondire la conoscenza del corpo umano. I linfociti (globuli bianchi) costituiscono la prima linea di difesa del corpo contro le infezioni e una migliore conoscenza del loro funzionamento permetterà una comprensione più ampia dell'eziologia di diverse malattie, tra cui il cancro e, in modo particolare, l'HIV - che colpisce specificamente i linfociti - e la leucemia. L'équipe del dipartimento di immunologia dell'Imperial College di Londra ha pubblicato negli atti della Royal Society i risultati ottenuti. Nel corso di esperimenti effettuati su pecore, i ricercatori sono stati in grado di marcare linfociti B utilizzando un colorante chiamato carbossifluoresceina diacetato succinimidil esterasi (CFSE). Questa sostanza marca tutti i linfociti dell'organismo ospite. I ricercatori hanno quindi svolto regolari esami del sangue nelle 11 settimane successive per capire cosa fosse accaduto a tali linfociti. In esperimenti di laboratorio condotti in passato, marcatori quali il BrdU e il glucosio deuterato venivano utilizzati per monitorare lo sviluppo dei linfociti in patologie quali l'infezione da HIV e la leucemia. Il problema di questi vecchi marcatori è che, dopo aver aderito al DNA vivo, essi si manifestano tipicamente al momento della divisione della cellula, impedendo di conoscere gran parte del ciclo vitale dei linfociti. Da qualche tempo si cerca di sviluppare una tecnica diversa per misurare accuratamente il tasso di mortalità delle cellule, così come la divisione e la proliferazione in tutto il corpo umano. Il nuovo metodo CFSE marca tutte le cellule con le quali viene a contatto e, quando una cellula si divide, la colorazione viene ripartita tra le due nuove cellule. La maggior parte dei risultati sarà pubblicata in futuro, ma una nuova scoperta è già stata resa nota: "Nei primi giorni la postmarcatura della maggior parte delle cellule marcate perdute non è dovuta alla morte delle cellule come spesso si crede, ma alla fuoriuscita di cellule non marcate dalla milza", si legge nel documento I ricercatori ritengono che combinando la CFSE e alcuni vecchi tipi di marcatura sarà possibile acquisire conoscenze più approfondite sulla vita dei linfociti. Se la marcatura con CFSE sembra favorire i linfociti a circolazione ridotta, le forme di marcatura utilizzate in passato preferiscono le cellule dei tessuti linfoidi. "Questo studio offre l'opportunità di utilizzare la CFSE in ambito fisiologico per determinare la cinetica dei linfociti in situ", sostengono i ricercatori.
Paesi
Belgio